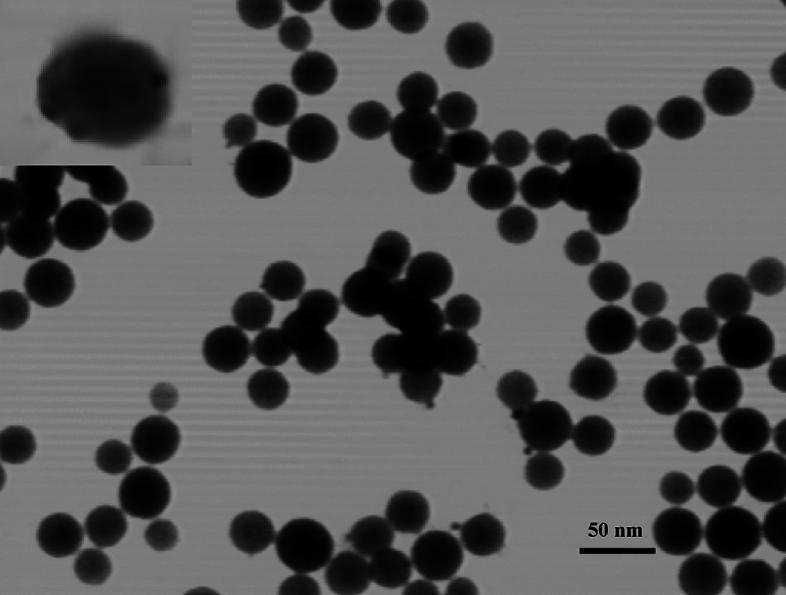

一种基于嵌入介孔SiO中的镍掺杂CsPbBr钙钛矿纳米晶体的高效化学发光探针,用于灵敏检测L-半胱氨酸。
An efficient chemiluminescent probe based on Ni-doped CsPbBr perovskite nanocrystals embedded in mesoporous SiO for sensitive assay of L-cysteine.
作者信息
Salari Rana, Amjadi Mohammad
机构信息
Department of Analytical Chemistry, Faculty of Chemistry, University of Tabriz, Tabriz, 5166616471, Iran.
出版信息
Sci Rep. 2024 Sep 6;14(1):20871. doi: 10.1038/s41598-024-70624-y.
This study presents an efficient chemiluminescence (CL) probe based on perovskite nanocrystals (NCs) for detection of L-cysteine (L-Cys). It consists of nickel-doped CsPbBr NCs embedded in the mesoporous SiO matrix as CL reagent and cerium (IV) as an oxidant in aqueous environment. The probe was designed for the highly selective determination of L-Cys based on its remarkable enhancing effect on the CL intensity. The colloidal nanocomposite of nickel-doped CsPbBr NCs@SiO with photoluminescence quantum yield of 58% was fabricated by ligand-assisted re-precipitation method and characterized by using UV-Vis absorption, FT-IR, X-ray diffraction, and transmission electron microscopy. The sensor was utilized to determine L-Cys in the linear concentration range of 20-300 nM with a detection limit of 12.8 nM. Direct chemical oxidation of Ni-doped CsPbBr NCs@SiO by Ce(IV) was the single cause of the formation of the excited-state NCs and subsequent production of CL. The developed probe provides outstanding selectivity towards L-Cys over structurally related compounds. Accurate determination of L-Cys in human serum samples was achieved without interference, and the results were confirmed by HPLC method.
本研究提出了一种基于钙钛矿纳米晶体(NCs)的高效化学发光(CL)探针,用于检测L-半胱氨酸(L-Cys)。它由嵌入介孔SiO基质中的镍掺杂CsPbBr NCs作为CL试剂,以及铈(IV)作为水性环境中的氧化剂组成。该探针基于L-Cys对CL强度的显著增强作用,设计用于高选择性测定L-Cys。通过配体辅助再沉淀法制备了光致发光量子产率为58%的镍掺杂CsPbBr NCs@SiO胶体纳米复合材料,并通过紫外-可见吸收、傅里叶变换红外光谱、X射线衍射和透射电子显微镜进行了表征。该传感器用于测定L-Cys,线性浓度范围为20-300 nM,检测限为12.8 nM。Ce(IV)对镍掺杂CsPbBr NCs@SiO的直接化学氧化是激发态NCs形成及随后产生CL的唯一原因。所开发的探针对L-Cys具有优于结构相关化合物的出色选择性。无需干扰即可准确测定人血清样品中的L-Cys,结果通过高效液相色谱法得到证实。